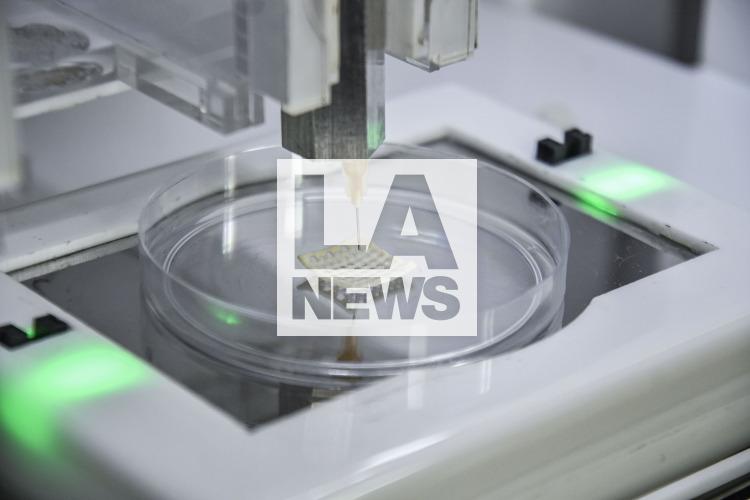
imagen principal

30 de Noviembre 2022
Buenos Aires,Argentina
2738 x 1825 px
30 de Noviembre 2022
Buenos Aires,Argentina
2738 x 1825 px
Buenos Aires, Argentina.- En las fotos tomadas el 29 de noviembre del 2022, científicos de la Facultad de Farmacia y Bioquímica de la UBA (FFyB) y el Conicet desarrollaron una biotinta que contiene aceite de cannabis para impresión 3D que puede utilizarse en la regeneración de tejidos o restauración de órganos dañado, lo que constituye una novedad a nivel mundial por el uso del derivado de esta planta con propiedades antimicrobianas y antioxidantes entre otros beneficios, además de ser biocompatible.
TagsAmérica , científicos , Argentina , Buenos Aires , cannabis , cannabis medicinal , América Latina